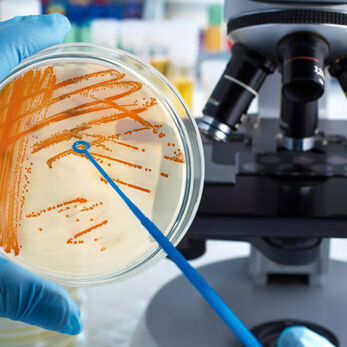
Cách phòng sạch thực phẩm giúp đáp ứng yêu cầu an toàn thực phẩm & xu hướng kiểm soát vi sinh mới

- Thách thức kiểm soát vi sinh với phòng sạch thực phẩm trong môi trường cực lạnh
- Cấu trúc phòng sạch thực phẩm cho môi trường đông lạnh tốc độ cao
- Công nghệ, quy trình kiểm soát vi sinh và lợi ích ứng dụng trong môi trường đông lạnh tốc độ cao
- Giải pháp thiết bị phòng sạch chuyên dụng đến từ Vietnamcleanroom (VCR)
Thách thức kiểm soát vi sinh với phòng sạch thực phẩm trong môi trường cực lạnh
Các nhà máy thực phẩm đông lạnh phải đối mặt với nhiều vấn đề kỹ thuật phức tạp khi vận hành phòng sạch ở nhiệt độ -40°C. Ở mức nhiệt này, mặc dù sự phát triển của vi sinh vật chậm lại nhưng không hoàn toàn bị loại bỏ, đặc biệt là các vi khuẩn tâm lạnh (psychrophilic bacteria) có khả năng tồn tại và phát triển. Hệ thống HVAC và luồng khí trong phòng sạch thực phẩm dễ gặp tình trạng đóng băng, gây tắc dòng khí và giảm hiệu suất lọc, đồng thời hình thành các điểm ẩn, nơi vi sinh vật có thể trú ẩn mà khó phát hiện. Việc duy trì áp suất dương hoặc âm ổn định trở nên khó khăn, đặc biệt khi luồng khí phải phân tách giữa các khu vực có nguy cơ nhiễm bẩn khác nhau, chẳng hạn khu sơ chế nguyên liệu so với khu đóng gói thành phẩm.
Ngoài ra, dung dịch khử trùng thông thường có thể đóng băng hoặc giảm hiệu quả khi áp dụng ở nhiệt độ cực thấp, do đó các nhà máy phải kết hợp nhiều giải pháp khử trùng khác nhau, bao gồm nhiệt, hóa chất chuyên dụng hoặc khí ozone/hydrogen peroxide, nhằm đảm bảo diệt khuẩn triệt để cả bề mặt và luồng khí. Luồng vận hành nguyên liệu, sản phẩm trung gian và thành phẩm cần được tối ưu hóa để giảm thời gian tiếp xúc và hạn chế rủi ro nhiễm khuẩn, đồng thời duy trì dây chuyền lạnh liên tục mà không làm gián đoạn sản xuất. Việc kiểm soát độ ẩm và ngưng tụ nước cũng là một thách thức lớn, vì hơi nước dễ hình thành băng trên bề mặt thiết bị, sàn và trần, tạo điều kiện cho vi sinh tích tụ.
Thêm vào đó, nhân sự vận hành trong môi trường lạnh sâu cũng phải thực hiện theo các quy trình nghiêm ngặt, với trang phục bảo hộ cách nhiệt, thao tác nhanh gọn và hạn chế tiếp xúc trực tiếp với nguyên liệu. Các điểm vệ sinh, găng tay và công cụ thao tác cần được khử trùng liên tục, và cảm biến giám sát phải hoạt động ổn định trong điều kiện nhiệt độ khắc nghiệt để cung cấp dữ liệu theo thời gian thực, giúp phát hiện sớm các bất thường về áp suất, dòng khí hoặc mức tải vi sinh.
Nhờ việc kết hợp chặt chẽ giữa thiết kế luồng khí, vật liệu chịu lạnh, công nghệ khử trùng và quy trình vận hành tối ưu, các nhà máy thực phẩm đông lạnh mới có thể duy trì môi trường sản xuất an toàn, giảm rủi ro vi sinh, đồng thời đảm bảo chất lượng sản phẩm trong điều kiện cực kỳ khắc nghiệt.

>>> Tìm hiểu thêm về: Các lõi lọc tiêu biểu trong phòng sạch thực phẩm từ Vietnamcleanroom (VCR)
Cấu trúc phòng sạch thực phẩm cho môi trường đông lạnh tốc độ cao
Phòng sạch thực phẩm trong môi trường đông lạnh tốc độ cao không chỉ đơn giản là một không gian kín, mà còn là một hệ thống kết hợp vật liệu chịu lạnh, thiết kế luồng khí tối ưu và công nghệ giám sát thông minh để đảm bảo vi sinh được kiểm soát tuyệt đối. Sàn, trần, panel và cửa được lựa chọn từ các vật liệu cách nhiệt, chống bám bẩn, chống đóng băng và dễ vệ sinh, đồng thời phải chịu được sốc nhiệt khi nguyên liệu hoặc thiết bị từ môi trường bên ngoài được đưa vào phòng. Những bề mặt này còn phải tương thích với các chất tẩy rửa chuyên dụng, đảm bảo vệ sinh nhanh chóng mà không làm hư hại vật liệu.
Hệ thống HVAC trong phòng sạch đông lạnh được thiết kế để duy trì áp suất ổn định, phân bố dòng khí theo mô hình một chiều tại các khu vực có nguy cơ nhiễm bẩn cao, đồng thời hạn chế tối đa khu vực chết khí. Luồng khí cần được kiểm soát chặt chẽ để giảm thất thoát nhiệt, đồng thời ngăn ngừa ngưng tụ nước và băng giá trên bề mặt thiết bị, trần và sàn. Bộ lọc HEPA/ULPA, cùng các tầng lọc tiền xử lý, được bố trí hợp lý để giảm tải cho hệ thống lọc chính, đảm bảo cả hiệu quả năng lượng lẫn chất lượng không khí.
Cảm biến giám sát nhiệt độ, độ ẩm, áp suất và lưu lượng khí phải hoạt động ổn định trong điều kiện cực lạnh, cung cấp dữ liệu theo thời gian thực để hệ thống tự động điều chỉnh thông số môi trường khi cần. Bên cạnh đó, thiết kế luồng di chuyển của con người và vật liệu trong phòng sạch cần được tối ưu hóa: khu vực sơ chế nguyên liệu, chiết rót sản phẩm và đóng gói thành phẩm được phân tách rõ ràng, luồng đi một chiều được áp dụng để hạn chế tối đa tiếp xúc và ô nhiễm thứ cấp. Thiết kế này còn giúp nhân viên vận hành dễ dàng kiểm soát quy trình, giảm số lần thay găng tay, giày và bộ đồ bảo hộ, từ đó nâng cao hiệu quả sản xuất mà vẫn đảm bảo an toàn.
Ngoài ra, các giải pháp bổ trợ như cửa khí Air Shower, buồng chuyển nguyên liệu (Pass Box) và hệ thống tiệt trùng bằng hydrogen peroxide hoặc tia UV được tích hợp linh hoạt để tiêu diệt vi sinh vật khi nguyên liệu hoặc sản phẩm di chuyển giữa các vùng khác nhau. Nhờ sự kết hợp đồng bộ giữa vật liệu, luồng khí, cảm biến thông minh và quy trình vận hành, phòng sạch cho thực phẩm đông lạnh tốc độ cao có thể duy trì môi trường an toàn, giảm thiểu rủi ro vi sinh, đồng thời đảm bảo chất lượng và độ ổn định của sản phẩm ngay cả ở nhiệt độ -40°C.

>>> Tìm hiểu thêm về: Tủ cách ly vô trùng giải pháp bảo vệ tuyệt đối cho môi trường sản xuất thực phẩm sạch
Công nghệ, quy trình kiểm soát vi sinh và lợi ích ứng dụng trong môi trường đông lạnh tốc độ cao
Để duy trì môi trường phòng sạch an toàn ở nhiệt độ -40°C, các nhà máy thực phẩm đông lạnh hiện đại cần kết hợp đồng bộ nhiều công nghệ và quy trình kiểm soát vi sinh. Hệ thống lọc HEPA/ULPA đảm bảo loại bỏ hạt bụi và vi sinh vật cực nhỏ, trong khi áp suất trong phòng được điều khiển chính xác để ngăn chặn sự xâm nhập của không khí bên ngoài, đồng thời tạo dòng khí một chiều ở các khu vực nhạy cảm. Các cảm biến thông minh theo dõi liên tục áp suất, nhiệt độ và độ ẩm, cung cấp dữ liệu theo thời gian thực để hệ thống tự động điều chỉnh, giảm tối đa rủi ro vi sinh tồn tại trong môi trường cực lạnh.
Quy trình tiệt trùng bằng tia UV hoặc hydrogen peroxide được áp dụng trước và sau mỗi chu kỳ sản xuất nhằm đảm bảo bề mặt, không khí và thiết bị luôn vô trùng, kết hợp với việc vận hành luồng di chuyển một chiều cho nguyên liệu, sản phẩm trung gian và nhân sự. Thiết kế modular hoặc linh hoạt cho phép các khu vực phòng sạch được mở rộng hoặc nâng cấp mà không gián đoạn sản xuất, đồng thời tối ưu hóa dòng khí, phân vùng cấp sạch hợp lý và giảm tải cho hệ thống HVAC, góp phần tiết kiệm năng lượng và chi phí vận hành dài hạn.
Ứng dụng thực tế cho thấy, các nhà máy sữa, chế biến thủy sản, đồ uống và thực phẩm chức năng khi áp dụng những nguyên tắc này có thể vận hành dây chuyền tự động liên tục, hạn chế tối đa tiếp xúc của con người với nguyên liệu và sản phẩm, từ đó giảm nguy cơ nhiễm vi sinh và ô nhiễm thứ cấp. Năng suất được cải thiện nhờ robot và hệ thống tự động hoạt động không ngừng, chi phí vận hành được tối ưu nhờ kiểm soát năng lượng thông minh, đồng thời chất lượng sản phẩm được duy trì ổn định, đáp ứng các tiêu chuẩn quốc tế nghiêm ngặt. Nhờ sự kết hợp giữa công nghệ, quy trình và thiết kế linh hoạt, phòng sạch thực phẩm đông lạnh tốc độ cao trở thành giải pháp bền vững, an toàn và hiệu quả cho các nhà máy hiện đại, giúp doanh nghiệp tăng năng lực sản xuất mà vẫn bảo vệ thương hiệu và sức khỏe người tiêu dùng.

Giải pháp thiết bị phòng sạch chuyên dụng đến từ Vietnamcleanroom (VCR)
Để đáp ứng yêu cầu nghiêm ngặt này, các doanh nghiệp nên lựa chọn thiết bị phòng sạch chất lượng cao, từ panel, HVAC, FFU, đến hệ thống lọc HEPA/ULPA và Air Shower. Các đơn vị như Vietnamcleanroom (VCR) có kinh nghiệm đồng hành cùng các nhà máy thực phẩm đông lạnh, tư vấn thiết kế cấu hình và lựa chọn thiết bị phù hợp, giúp duy trì môi trường sản xuất an toàn, ổn định và đạt chuẩn quốc tế. Sự đầu tư đúng đắn vào thiết bị và quy trình sẽ tối ưu hóa hiệu quả vận hành, kéo dài tuổi thọ thiết bị và nâng cao uy tín thương hiệu trên thị trường.